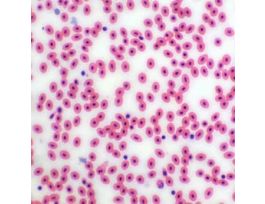
Prepared Slide, Frog Blood Smear

Need Help?
800-229-7252
Instruments & Meters
-
-
-
Prepared Microscope Slide Set, Basic Botany Models, Set of 25 Slides; 1/EAEW-78908-52CPEW-78908-52-EA -
Prepared Microscope Slide Set, Basic Plant Anatomy, Set of 20 Slides; 1/EAEW-78908-54CPEW-78908-54-EA -
-
-
-
-
-
-
-
-
-
-
Prepared Microscope Slide Set, Protozoa and Algae, Set of 20 Slides; 1/EAEW-78908-55CPEW-78908-55-EA -
-